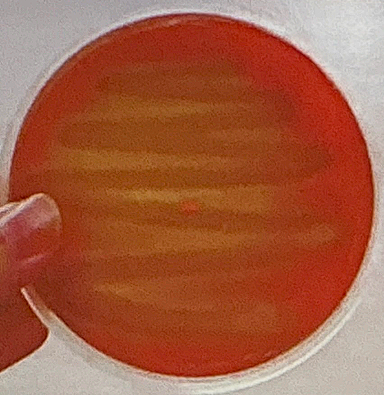
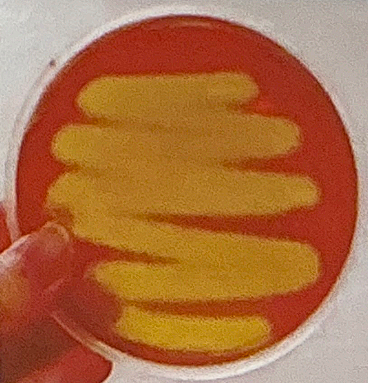

Hemolisis de Streptococci…
Hay α, β y γ
α hemolisis
Hemolisis parcial
β hemolisis
Hemolisis completa
γ hemolisis
No tiene hemolisis

Bicho sensible a Optoquina
S. pneumoniae
Bicho resistente a Optoquina
S. viridians
Bicho sensible a Bacitracina
S. pyogenes
Bicho resistente a Bacitracina
S. agalactatiae
Bichos con α hemolisis
S. viridian y S. pneuomoniae
Bichos con β hemolisis
S. agalactiae y S. pyogenes
Bichos con γ hemolisis
Enterococci y no enterococcus
Streptococcus del grupo B
S. agalactiae
Streptococcus del grupo A
S. pyogenes
Streptococcus del grupo D
Enterococci
Características microbiologicas de streptococcus…
-Cocos gram +
-Pares (diplococos o cadenas)
-Anaerobios facultativos
-Catalasa negativos

Característica importante de la cápsula…
Ayuda a atravesar la barrera hematoencefalica, lo que ayuda a la meningitis


